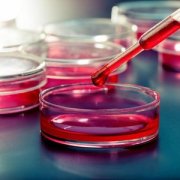
Ѫ֬����֢״����Щ Ѫ֬����֢״����

-
治脂肪肝怎样把握运动量 哪些运动适合脂肪肝
脂肪肝是由于多种原因引起的肝细胞内脂质蓄积过多的一种病理状态,这种疾病是可以逆转的。在治疗过程中主要以饮食注意和加强锻炼为主,因为脂肪肝通常偏爱懒人。下面我们就来看看治脂肪肝怎样把握运动量。 治脂肪肝怎样把握运动量 在许多治疗措施中,需要特...
2017-06-03 04:49 -
肝硬化患者如何进行自我管理
肝硬化是慢性肝病的晚期阶段,病人会出现各种并发症和肝脏功能的异常,病情在活动期或有严重的并发症需要住院治疗,当病情相对稳定的时候,病人就可以出院调养。病人的大部分时间还是在家里,下面就来看看肝硬化患者如何进行自我管理。 肝硬化患者如何进行自...
2017-06-03 03:43 -
月经周期怎么算 解析女性生理周期
你知道月经周期怎么算吗?一起来看看吧. 月经周期 月经是一个妇女在整个生殖生命中,周期性的阴道排血或子宫出血。每隔一个月左右,子宫内膜发生一资助增厚,血管增生、腺体生长分泌以及子宫内膜崩溃脱落并伴随出血的周期性变化,这种生理上的循环周期就叫做...
2017-06-03 02:18 -
尿路结石病人的饮食禁忌 尿路结石病人饮食注意
尿路结石病人的饮食一般就要注意饮食了,下面我们就来看看尿路结石病人的饮食禁忌。 尿路结石病人的饮食禁忌 1.菠菜 菠菜中包含比较多的草酸,容易造成高草酸尿。对于原来草酸钙处于饱和状态的尿液。吃菠菜后可以使草酸成倍增长。这样就增加了形成与加重尿路...
2017-06-03 00:24 -
血脂稠的症状有哪些 血脂稠的症状表现
对于血脂稠这方面的疾病,一般大多数情况都是出现在肥胖者的身上的,很多人对于这方面的概论都是比较模糊的,接下来就来给大家介绍一下血脂稠的症状有哪些。 血脂稠的症状有哪些 1症状一:主要是脂质在真皮内沉积所引起的黄色瘤和脂质在血管内皮沉积所引起的...
2017-06-02 17:27 -
男性肾炎的早期症状 肾炎怎么办
男性肾炎的早期症状有哪些?相信大家对肾炎都不会感到陌生了,肾炎在时间上可分为急性肾炎和慢性肾炎,下面就为大家介绍一下关于肾炎的知识,希望能为大家带来帮助。 男性肾炎的早期症状 男性肾炎的早期症状: 一、男性患者在早期的时候一般会出现浮肿,一般...
2017-06-02 15:49 -
肝囊肿有哪些症状 肝囊肿的表现
肝囊肿是一种常见的良性疾病,多由先天因素导致,但是很多患者由于对肝囊肿的表现不了解,以致不能及早就诊。下面就来看看肝囊肿有哪些症状。 肝囊肿有哪些症状 压迫症状: 囊肿压迫胃部患者不敢正常进食或饱餐,挤压心脏时可以出现心衰,有的病人因为肝左叶...
2017-06-02 14:36 -
怎么快速缓解胃痛 家庭治胃疼的小妙招
长期加班工作、饮食作息不规律都很容易就会引起胃痛,你知道怎么快速缓解胃痛吗?家庭治胃疼的小妙招一起来看看吧! 怎么快速缓解胃痛 1.精神胜利法 胃痛在发作的时后一定要稳...
2017-06-02 11:15 -
急性盆腔炎 详解急性盆腔炎病因及症状
你知道急性盆腔炎吗?一起来看看吧. 急性盆腔炎 盆腔器官解剖图女性盆腔生殖器官及其周围的结缔组织、盆腔腹膜发生炎症时,称为盆腔炎,包括子宫炎、输卵管卵巢炎、盆腔结缔组织炎及盆腔腹膜炎,可一处或几处同时发病,是妇女常见病之一。由于输卵管、卵巢统...
2017-05-19 01:32 -
肝病的症状有哪些 肝区不适上消化道出血
肝病是指发生在肝脏的病变。包括乙肝,甲肝,丙肝,肝硬化,脂肪化,肝癌,酒精肝等等多种肝...
2017-05-19 00:00
 关注我们
关注我们

排行榜
排行榜
 编辑推荐
编辑推荐



